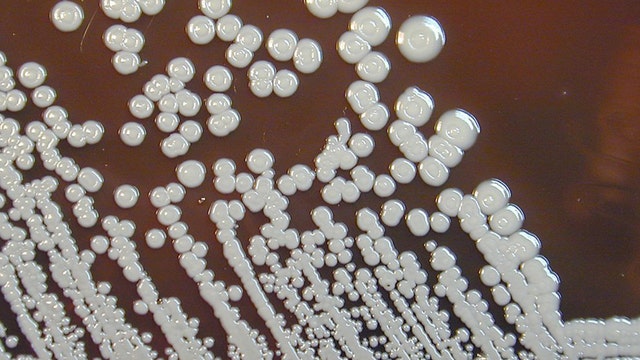
Melioidosis: CDC says 4 infected, 2 dead in US from rare tropical disease

With masks optional, Pinellas students head to campus on first day of school
The new school year is officially underway in all of the Bay Area as classes in Pinellas County begin Wednesday.
The new school year is officially underway in all of the Bay Area as classes in Pinellas County begin Wednesday.
Full FDA approval of Pfizer-BioNTech vaccine expected in September
Usually, full FDA approval takes 10 months. Pfizer-BioNTech submitted its application this summer for full approval and it’s being fast-tracked because of the pandemic.
Usually, full FDA approval takes 10 months. Pfizer-BioNTech submitted its application this summer for full approval and it’s being fast-tracked because of the pandemic.
Melioidosis: CDC says 4 infected, 2 dead in US from rare tropical disease
U.S. health officials are investigating the latest fatal case of a rare tropical disease typically found in South Asia.
U.S. health officials are investigating the latest fatal case of a rare tropical disease typically found in South Asia.
Emergency ventilators, lines of ambulances waiting for open beds at Pinellas County hospitals
At least one hospital in Pinellas County has made an emergency request for ventilators as hospitals are overrun by COVID-19 patients.
At least one hospital in Pinellas County has made an emergency request for ventilators as hospitals are overrun by COVID-19 patients.
Sarasota schools: No field trips, visitors for 30 days due to COVID-19
Due to the increased community spread of COVID-19 in Sarasota County, school officials have suspended field trips and visitors for 30 days.
Due to the increased community spread of COVID-19 in Sarasota County, school officials have suspended field trips and visitors for 30 days.
Florida sets new COVID-19 hospitalization record, topping 14,700
While the Florida Department of Health has not yet made its daily report of new COVID-19 cases to the Centers for Disease Control and Prevention, the Florida Hospital Association is reporting a record number of patients hospitalized with the virus.
While the Florida Department of Health has not yet made its daily report of new COVID-19 cases to the Centers for Disease Control and Prevention, the Florida Hospital Association is reporting a record number of patients hospitalized with the virus.
AstraZeneca COVID-19 vaccine nasal spray effective in animals, NIH says
NIH researchers are currently testing a nasal spray version of the AstraZeneca COVID-19 vaccine that has proven effective in hamsters and monkeys.
NIH researchers are currently testing a nasal spray version of the AstraZeneca COVID-19 vaccine that has proven effective in hamsters and monkeys.
CARES Act funds could be used to pay salaries of school officials who impose mask mandates: White House
White House Press Secretary Jen Psaki said Tuesday that CARES Act funds could be used to pay school administrators whose salaries were withheld over imposing mask mandates in school districts.
White House Press Secretary Jen Psaki said Tuesday that CARES Act funds could be used to pay school administrators whose salaries were withheld over imposing mask mandates in school districts.
US records more than 184,000 new COVID-19 cases in 24 hours
The U.S. recorded 184,346 new daily COVID-19 cases over 24 hours amid a surge driven by the delta variant and low vaccination rates across the South and in other areas.
The U.S. recorded 184,346 new daily COVID-19 cases over 24 hours amid a surge driven by the delta variant and low vaccination rates across the South and in other areas.
Colorado county hit early by COVID-19 delta strain saw more breakthrough cases, CDC says
Mesa County in Colorado was hit early by the delta variant of the COVID-19 virus and experienced higher rates of breakthrough cases in vaccinated people, according to a CDC report.
Mesa County in Colorado was hit early by the delta variant of the COVID-19 virus and experienced higher rates of breakthrough cases in vaccinated people, according to a CDC report.
Hillsborough still tracking mask opt-outs as students return to school
The district will send principals and teachers daily updates on which of their students submitted the “opt out” form. But if they see a child who isn’t on their list without a mask, they won’t initially enforce the mandate.
The district will send principals and teachers daily updates on which of their students submitted the “opt out” form. But if they see a child who isn’t on their list without a mask, they won’t initially enforce the mandate.
When will kids be able to get the COVID-19 vaccine?
As children head back to school, the federal government is facing growing pressure from physicians and parents to approve COVID-19 vaccines for children under the age of 12.
As children head back to school, the federal government is facing growing pressure from physicians and parents to approve COVID-19 vaccines for children under the age of 12.
Could parents sue if a child gets COVID-19 from an unvaccinated teacher? Legal experts weigh in
As children return to school, parents are concerned with how best to protect their child from COVID-19. Legal experts say even if a child does get sick, it’ll be hard to place the blame on educators.
As children return to school, parents are concerned with how best to protect their child from COVID-19. Legal experts say even if a child does get sick, it’ll be hard to place the blame on educators.
First day of school is here for many students across Bay Area
A lot of alarm clocks rang for the first time in months as students in nearly every Bay Area district returned to class Tuesday morning.
A lot of alarm clocks rang for the first time in months as students in nearly every Bay Area district returned to class Tuesday morning.
DeSantis continues bucking mask mandates; Castor urges vaccination for eligible kids
Gov. DeSantis continues to threaten action against schools that go against 'parents' rights' when it comes to masks.
Gov. DeSantis continues to threaten action against schools that go against 'parents' rights' when it comes to masks.
Florida education commissioner ramps up DeSantis' threat to school officials over mask mandates
Two Florida counties have decided to require parents to submit doctors' notes if they want their children to be exempt from wearing masks. Now state Education Commissioner Richard Corcoran says he will enforce Gov. DeSantis' threat to withhold the salaries of school officials in Alachua and Leon counties.
Two Florida counties have decided to require parents to submit doctors' notes if they want their children to be exempt from wearing masks. Now state Education Commissioner Richard Corcoran says he will enforce Gov. DeSantis' threat to withhold the salaries of school officials in Alachua and Leon counties.
Some ambulances forced to wait outside as Florida hospitals deal with rising number of patients
Pinellas County officials say some hospitals have so many COVID-19 cases that patients in ambulances may have to wait for up to an hour before the hospital can admit them. Although the most serious cases, like heart attacks and strokes, still take priority, the situation is putting a strain on fire departments and hospitals alike.
Pinellas County officials say some hospitals have so many COVID-19 cases that patients in ambulances may have to wait for up to an hour before the hospital can admit them. Although the most serious cases, like heart attacks and strokes, still take priority, the situation is putting a strain on fire departments and hospitals alike.
Florida to appeal 'vaccine passport' ruling that said Norwegian cruises could require proof of vaccinations
Gov. DeSantis plans to appeal a federal judge's ruling that sided with Norwegian Cruise Lines in their constitutional challenge to Florida's ban on "vaccine passports." The ruling cleared the way for the cruise line to require passengers to show proof of COVID-19 vaccination.
Gov. DeSantis plans to appeal a federal judge's ruling that sided with Norwegian Cruise Lines in their constitutional challenge to Florida's ban on "vaccine passports." The ruling cleared the way for the cruise line to require passengers to show proof of COVID-19 vaccination.
Surfside first responders among first to receive $1,000 bonuses in Florida
Back in March, discussions began to include $1,000 bonuses to Florida’s first responders in the state budget. This week, some of those checks were hand-delivered to them.
Back in March, discussions began to include $1,000 bonuses to Florida’s first responders in the state budget. This week, some of those checks were hand-delivered to them.
Polk County’s first day of school opens with three new public schools
Willow Oak Elementary in Mulberry is one of three new schools opening Polk County on Tuesday, along with Davenport High and Bella Citta Elementary.
Willow Oak Elementary in Mulberry is one of three new schools opening Polk County on Tuesday, along with Davenport High and Bella Citta Elementary.